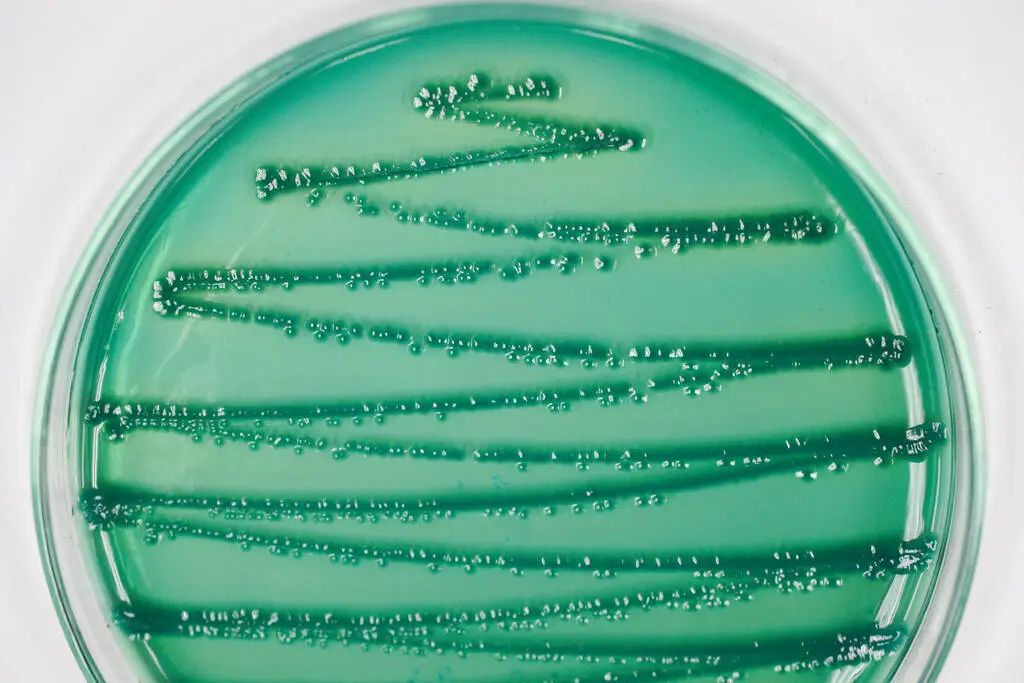
图片

万千商家帮你免费找货
0 人在求购买到急需产品
- 详细信息
- 文献和实验
- 技术资料
1、基因组DNA,要求琼脂糖检测有主带,不低于20ul,浓度不低于50ng/μL;
2、细菌:经菌种分离后带有单菌落的新鲜平板或斜面;
真菌/酵母菌:经菌种分离后斜面;
3、由于革兰氏阳性细菌的细胞壁较厚,请提供基因组DNA;
4、对于特殊菌种(如厌氧菌、放线菌等),请详细加以说明;
5、样本建议您使用冰袋运输;
6、如果测序结果出现背景峰或套峰,视为样品不纯,本公司将收取全额试验费用。
1、提供报告,和比对结果;
2、如果需要构建系统发育树,请在获得结果后将相关其他序列发给我们,一起构建。
★试验周期:
1~2周,样本量大请来电咨询。

风险提示:丁香通仅作为第三方平台,为商家信息发布提供平台空间。用户咨询产品时请注意保护个人信息及财产安全,合理判断,谨慎选购商品,商家和用户对交易行为负责。对于医疗器械类产品,请先查证核实企业经营资质和医疗器械产品注册证情况。
 文献和实验
文献和实验Western Blot 实验 通过SDS-PAGE胶将不同的分子量的蛋白分离开,将目标蛋白转移到PVDF膜上,再利用抗原抗体的特异性结合,用特异性的一抗结合目标蛋白,用HRP标记的二抗结合一抗,再加以ECL发光液显色,检测目的蛋白在不同处理的样本中表达量的高低变化 服务优势及实验服务流程: 1、利用高性能试剂配合高通量全自动western blot机,提供超高灵敏性的western blot实验服务。超高灵敏度最低至15飞克抗原。 2、一抗的寄送需要泡沫盒加冰袋低温即送
相关专题 分子生物学技术已经成为生命科学领域研究有力工具,但是很多实验的重复性和复杂性常会耗费很多时间,严重影响了实验的进度。所以现在很多课题组将实验中某些费事的实验环节外包给生物学技术服务 商。 1.哈尔滨海基生物科技有限公司 现代分子生物学技术已经成为科学研究领域有力的工具。但是,繁杂和重复性的工作花费了科研人员太多不必要的宝贵时间。将这些工作交给专业团队就能够大大节省实验人员的时间,提高
基化分析,是不同于基因芯片检测方法(检测位点多,样本少)的高通量方法。同时,也是基因芯片筛选后的多个基因在更多标本中验证的最佳方法。 - 苏州为真生物医药---国内唯一HRM技术服务提供商 ♦ 免费的项目咨询 ♦ 客户提供样本DNA的分离、纯化(可有为真公司代为提取) ♦ 根据客户提供相关信息进行引物设计、方案设计 ♦ 处理DNA并运用HRM技术获得特异溶解曲线 ♦ 结果分析,出具实验报告,为临床用药提供依据
 技术资料
技术资料暂无技术资料 索取技术资料










